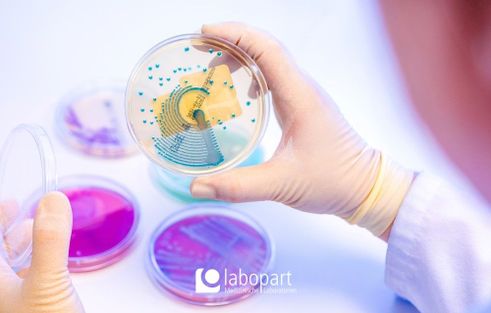

Medizinisch-technischer Laborassistent (m/w/d) in Chemnitz
Angestellte/r
Labor, Forschung
labopart ist ein unabhängiger medizinischer Laborverbund, der sich um die standortnahe Laborversorgung von Arztpraxen, MVZ und Krankenhäusern im Raum Dresden, Elsterwerda, Chemnitz und Leipzig kümmert. Mit einem kontinuierlich wachsenden Team, flachen Hierarchien und der Möglichkeit zur Verwirklichung eigener Ideen optimieren wir fortlaufend unsere Angebote.
Für den Bereich Klinische Chemie / Immunologie am Standort in Chemnitz suchen wir ab sofort einen Medizinisch-technischen Assistenten / Laborassistenten (m/w/d).
Aufgaben
- Tätigkeit in der Routinediagnostik
Qualifikation
- erfolgreich abgeschlossene Ausbildung als MTA / MTLA
- konzentrierte, strukturierte und selbständige Arbeitsweise
- Teamfähigkeit und Belastbarkeit
- Berufserfahrung wünschenswert, jedoch nicht zwingend erforderlich
Benefits
- interessanter, abwechslungsreicher und sicherer Arbeitsplatz
- gründliche Einarbeitung und Mitarbeit in einem engagierten Team
- Urlaubs- und Weihnachtsgeld
- bis zu 30 Tage Urlaub sowie Sonderurlaubstage
- Teilnahme an Fortbildungen
Wir freuen uns, Sie kennenzulernen.
Aktualisiert: vor 5 Minuten
Job ID 15847565
Problem melden

labopart - Medizinische Laboratorien
51-200 Mitarbeitende
Medizinische und diagnostische Labore
labopart ist ein unabhängiger medizinischer Laborverbund, der sich um die standortnahe Laborversorgung von Arztpraxen, MVZ und Krankenhäusern im Raum Dresden, Elsterwerda, Chemnit…
Mehr lesen



+
2 mehr